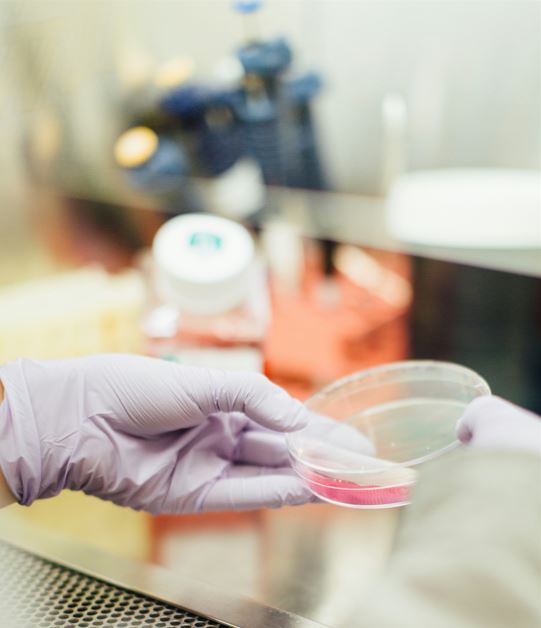

Buna guvernare în raionul tău. Dezbateri la Rezina: APL, Cetățeni, Mass-media și societatea civilă.
🔺Urmăriți seria dezbaterilor marca ASSIST Analytics pe postul de televiziunel ELITA TV și fiți informați despre nivelul bunei guvernări în raionul tău! În prima ediție, aflăm ce spun participanții la dezbateri despre situația la Rezina. VIDEO. Ne găsiți în toată țara pe canalele 901 -Moldtelecom, 40 -Starnet și alți distribuitori...